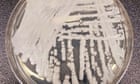

From the archive: My four miscarriages: why is losing a pregnancy so shrouded in mystery? – podcast
We are exploring the Guardian Long Read archives to bring you some classic pieces from years past, with new introductions from the authors.This week, from 2020: After losing four pregnancies, Jennie Agg set out to unravel the science of miscarriage. Then, a few months in, she found out she was pregnant again – just as the coronavirus pandemic hit Continue reading...